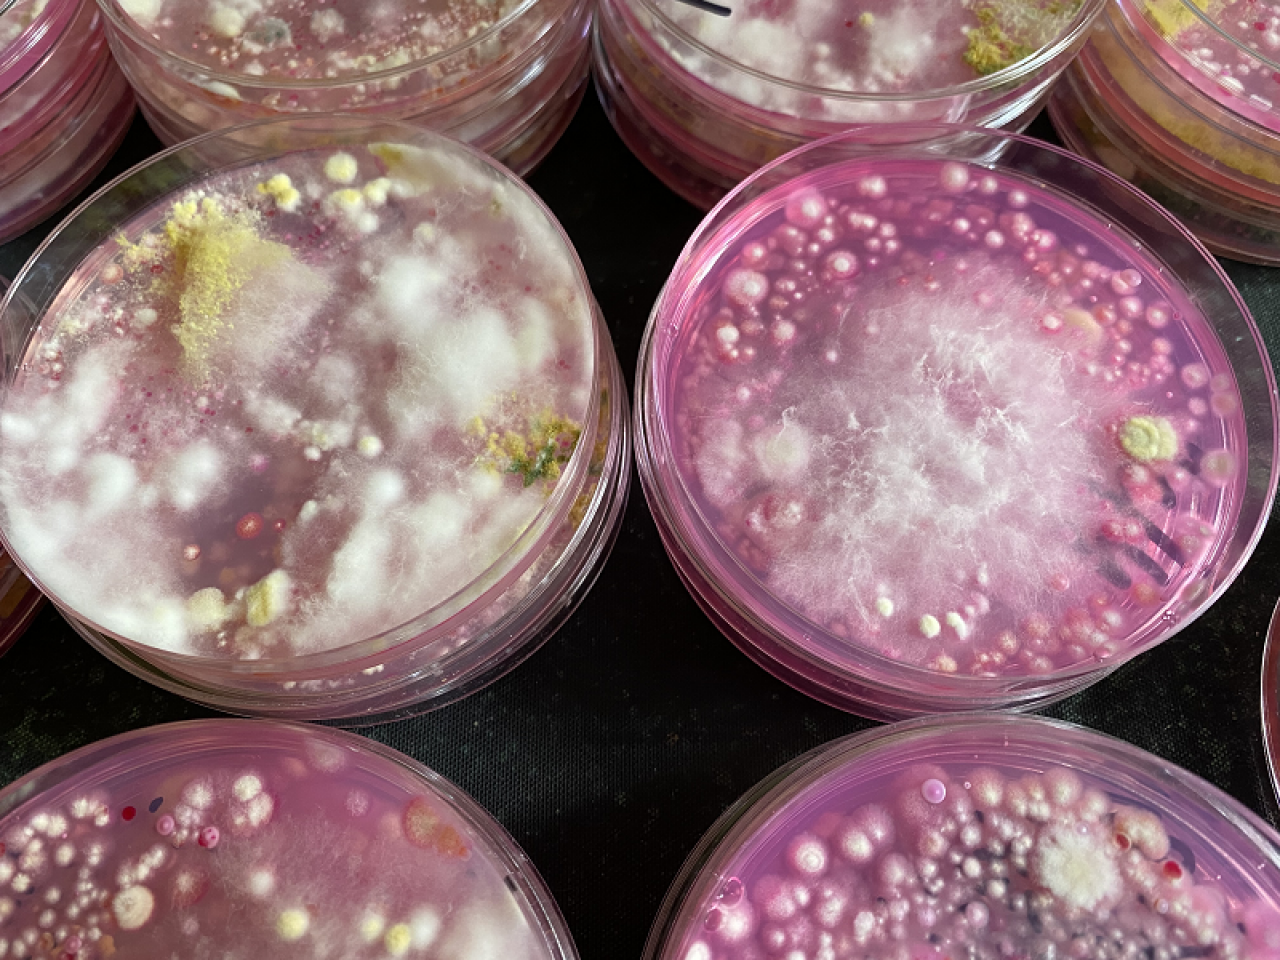
192869

Mikroorganizmy odgrywają bardzo ważną rolę w uprawie roślin. W obliczu postępujących zmian klimatu należy zadbać o zachowanie wysokiej bioróżnorodności w środowisku glebowym. Zmiany klimatyczne wpływają w sposób bezpośredni i pośredni na interakcje zachodzące między mikroorganizmami oraz mikroorganizmami a roślinami. W konsekwencji mogą zmieniać lub nawet zaburzać funkcje ekosystemu glebowego, takie jak magazynowanie dwutlenku węgla, produktywność i żyzność gleby. Poważnym zagrożeniem jest utrata bioróżnorodności mikrobiologicznej gleb spowodowana m.in. suszą, wysoką temperaturą, okresowym zalaniem pól. W warunkach stresu rozwój wyspecjalizowanych mikroorganizmów, min. grzybów mykoryzowych czy bakterii wspomagających wzrost roślin zostaje zaburzony. Dochodzi do ilościowych i jakościowych zmian w populacjach mikroorganizmów. W konsekwencji procesy wpływające na aktywność biologiczną i żyzność gleb mogą ulec intensyfikacji lub zahamowaniu.
Wtórne wykorzystanie materii organicznej
Zmiany klimatyczne mogą wpływać negatywnie na zawartość materii organicznej w glebie, powodować zwiększoną mineralizacje materii organicznej, emisję gazów cieplarnianych, zwiększać intensywność procesów denitryfikacyjnych i przyczyniać się do wzrostu strat azotu. Dlatego ważnym elementem upraw, poprawiającym bioróżnorodność mikrobiologiczną gleb, jest wtórne wykorzystanie materii organicznej powstałej w danym gospodarstwie lub wykorzystywanie innych typów materiałów organicznych, które aktywizują procesy mikrobiologiczne, podnoszące produktywność i żyzność gleby oraz pozwalające na utrzymanie właściwej jej struktury i właściwości retencyjnych, w warunkach wydłużonych okresów niedoboru wody.
Wzbudzanie naturalnej odporności roślin
W ochronie upraw ważnym elementem jest również wzbudzanie naturalnej odporności roślin. W tym procesie ogromny wpływ odgrywają mikroorganizmy żyjące w strefie korzeniowej, m.in. bakterie z rodzajów Bacillus i Pseudomonas lub grzyby Trichoderma, grzyby mykoryzowe, ale także endofity – mikroorganizmy żyjące wewnątrz tkanek roślin. Mikroorganizmy te w warunkach stresów wywoływanych zmianami klimatycznymi indukują w roślinie mechanizmy adaptacyjne (morfologiczne, biochemiczne i fizjologiczne). Aktywność biologiczną w uprawach można optymalizować poprzez użycie preparatów mikrobiologicznych. Warto jednak zaznaczyć, że ich skuteczność w niestabilnych warunkach klimatycznych może być zakłócona. Zdecydowanie łatwiej i dokładniej technicznie można przeprowadzić traktowanie roślin w warunkach kontrolowanych (np. uprawy pod osłonami) zarówno w postaci oprysku, czy doglebowo. W warunkach polowych, susza i upały lub ulewne deszcze mogą pogarszać skuteczność preparatów biologicznych.
Mikroorganizmy chorobotwórcze
Poważnym problemem w warunkach zmieniającego się klimatu mogą stać się mikroorganizmy chorobotwórcze dla człowieka (np. Escherichia coli, Salmonella spp., Listeria monocytogenes), zanieczyszczające owoce i warzywa. Źródłem tych skażeń są głównie nawozy naturalne, woda, odchody dzikich zwierząt. Zagrożeniem są także nowe patogeny roślin, zawleczone z innych krajów.
Dr Beata Kowalska, IO w Skierniewicach, fot. IO